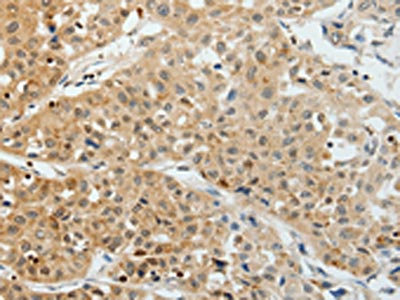

VEGFA Antibody
-
中文名稱:VEGFA兔多克隆抗體
-
貨號(hào):CSB-PA379558
-
規(guī)格:¥1100
-
圖片:
-
The image on the left is immunohistochemistry of paraffin-embedded Human lung cancer tissue using CSB-PA379558(VEGFA Antibody) at dilution 1/25, on the right is treated with synthetic peptide. (Original magnification: ×200)
-
The image on the left is immunohistochemistry of paraffin-embedded Human cervical cancer tissue using CSB-PA379558(VEGFA Antibody) at dilution 1/25, on the right is treated with synthetic peptide. (Original magnification: ×200)
-
Gel: 12%SDS-PAGE, Lysate: 40 μg, Lane 1-4: Hela cells, Jurkat cells, 293T cells, 231 cells, Primary antibody: CSB-PA379558(VEGFA Antibody) at dilution 1/300, Secondary antibody: Goat anti rabbit IgG at 1/8000 dilution, Exposure time: 50 seconds
-
-
其他:
產(chǎn)品詳情
-
Uniprot No.:
-
基因名:
-
別名:glioma-derived endothelial cell mitogen antibody; MGC70609 antibody; MVCD1 antibody; Vascular endothelial growth factor A antibody; Vascular Endothelial Growth Factor antibody; Vascular permeability factor antibody; VEGF antibody; VEGF-A antibody; VEGF165 antibody; Vegfa antibody; VEGFA_HUMAN antibody; VPF antibody
-
宿主:Rabbit
-
反應(yīng)種屬:Human
-
免疫原:Synthetic peptide of Human VEGFA
-
免疫原種屬:Homo sapiens (Human)
-
標(biāo)記方式:Non-conjugated
-
抗體亞型:IgG
-
純化方式:Antigen affinity purification
-
濃度:It differs from different batches. Please contact us to confirm it.
-
保存緩沖液:-20°C, pH7.4 PBS, 0.05% NaN3, 40% Glycerol
-
產(chǎn)品提供形式:Liquid
-
應(yīng)用范圍:ELISA,WB,IHC
-
推薦稀釋比:
Application Recommended Dilution ELISA 1:2000-1:5000 WB 1:500-1:2000 IHC 1:25-1:100 -
Protocols:
-
儲(chǔ)存條件:Upon receipt, store at -20°C or -80°C. Avoid repeated freeze.
-
貨期:Basically, we can dispatch the products out in 1-3 working days after receiving your orders. Delivery time maybe differs from different purchasing way or location, please kindly consult your local distributors for specific delivery time.
-
用途:For Research Use Only. Not for use in diagnostic or therapeutic procedures.
相關(guān)產(chǎn)品
靶點(diǎn)詳情
-
功能:Growth factor active in angiogenesis, vasculogenesis and endothelial cell growth. Induces endothelial cell proliferation, promotes cell migration, inhibits apoptosis and induces permeabilization of blood vessels. Binds to the FLT1/VEGFR1 and KDR/VEGFR2 receptors, heparan sulfate and heparin. NRP1/Neuropilin-1 binds isoforms VEGF-165 and VEGF-145. Isoform VEGF165B binds to KDR but does not activate downstream signaling pathways, does not activate angiogenesis and inhibits tumor growth. Binding to NRP1 receptor initiates a signaling pathway needed for motor neuron axon guidance and cell body migration, including for the caudal migration of facial motor neurons from rhombomere 4 to rhombomere 6 during embryonic development.
-
基因功能參考文獻(xiàn):
- These results not only call into question the use of VEGFA alone in bone regeneration, but also highlight the importance in BTE of appropriately formulated combined delivery of VEGFA and BMP2. PMID: 29386057
- VEGF and IL-8 play a prominent role in the pathogenesis of early forms of rosacea and the hemostasis system. PMID: 29578433
- The Novel Short Isoform of Securin Stimulates the Expression of Cyclin D3 and Angiogenesis Factors VEGFA and FGF2, but Does Not Affect the Expression of MYC Transcription Factor PMID: 29989583
- these results show peripheral blood levels of VEGF are significantly increased in colorectal patients PMID: 29924680
- Study found that VEGF-A expression in the epidermis associated to the mechanism of facial reddened skin. PMID: 28677138
- Quantitative analysis of VEGF-121 isoform in the plasma of patients with recurrent glioblastoma could be a promising predictor of response to anti-angiogenetic treatment. PMID: 29747600
- Study evaluated for the first time the plasma levels and the diagnostic usefulness of VEGF, MMP-9, and TIMP-1 in cervical cancer (CC), not only independently but especially in combination with established cervical tumor markers. All tested parameters showed statistical significance when compared their concentrations in patients with CC to healthy women. PMID: 30037277
- Results showed that VEGF expression level was upregulated in gallbladder cancer (GBC) tissues and cell lines under a hypoxic condition. PMID: 30272364
- these results indicate that sFlt-1 up-regulation by VEGF may be mediated by the VEGF/Flt-1 and/or VEGF/KDR signaling pathways. PMID: 29497919
- lncRNA TDRG1 may promote endometrial carcinoma cell proliferation and invasion by positively targeting VEGF-A and modulating relative genes. PMID: 29920344
- The data of this study indicated that the L-VEGF144 protein is not only a novel nucleolus protein but is likely to act as a mitogen to induce the proliferation of cancer cells. PMID: 29909500
- Study shows that vascular endothelial growth factor A stimulates STAT3 activity via nitrosylation of myocardin to regulate the expression of vascular smooth muscle cell differentiation markers. PMID: 28572685
- There is no association between the studied VEGF-A single nucleotide variations and the responses to intravitreal ranibizumab therapy in diabetic macular edema. However, the VEGF-A rs833069 gene polymorphism has a clear association with the severity of diabetic retinopathy. PMID: 29030794
- None of the investigated VEGF-A gene polymorphisms was found to be an independent prognostic marker for infantile hemangioma. However, there is evidence that individuals carrying at least one G allele of +405 G/C VEGF-A polymorphism have significantly lower risk of IH. PMID: 29984822
- This study showed that CIC haplotype of VEGF gene may be important risk factor for urothelial bladder cancer development in Tunisia. PMID: 29959793
- FABP5 promotes tumor angiogenesis via activation of the IL6/STAT3/VEGFA signaling pathway in hepatocellular carcinoma. PMID: 29957468
- This study did not identify a different VEGF 936CT genotype profile for patients with CHM who undergo SR versus those who progress to gestational trophoblastic neoplasia. However, the, results do suggest that this polymor- phism may affect susceptibility to complete hydatidiform-mole. Larger groups may improve the results of assessments of the predictive parameters of gestational trophoblastic neoplasia. PMID: 30383950
- there may be an association between rs6993770 polymorphism of VEGF and Metabolic Syndrome PMID: 29891039
- The data supports the assumption that C9 gene expression may stimulate the expression of inflammatory (NLRP3) and angiogenic growth factors (VEGF) in retinal pigment epithelial cells. PMID: 30090015
- DEC2 could upregulate retinal VEGF gene expression through modulation of HIF1alpha levels under hypoxic conditions. PMID: 30250985
- High expression of VEGF is associated with Oral Invasive Carcinomas. PMID: 30049191
- High VEGF expression is associated with angiogenesis of esophageal squamous cell carcinoma. PMID: 30015941
- VEGF-A was over-expressed in hypoxic glioblastoma-derived exosomes, which enhance the permeability of a blood-brain barrier in vitro model by interrupting the expression of claudin-5 and occludin. PMID: 29787762
- Single CpG methylation appears to enhance VEGF G4 thermostability in a manner dependent on both the CpG methylation site and cation type PMID: 29940278
- shear stress was able to induce arterial endothelial differentiation of stem cells from human exfoliated deciduous teeth, and VEGF-DLL4/NotchEphrinB2 signaling was involved in this process. PMID: 30015843
- Data indicate that CD147 promotes breast cancer cell proliferation, metastasis, and invasion by modulating matrix metalloproteinase 9 (MMP-9) and vascular endothelial growth factor (VEGF) expression. PMID: 29901696
- Our data demonstrated that the expression of VEGF was significantly related to the tumor incidence, metastasis and prognosis of patients with gastric cancer, which provides new leads to the diagnosis of gastric cancer. PMID: 29914006
- High VEGFA expression is associated with increased lymphangiogenesis and lymph node metastasis in prostate adenocarcinoma. PMID: 29544697
- VEGF/PKD-1 signaling axis increases angiogenic and arteriogenic gene expression. These studies suggest that the axis may regulate arteriolar differentiation through changing microvascular endothelial cells gene expression. PMID: 29380239
- widely stained in sclerosing stromal tumours of the ovary PMID: 29433373
- Study shows how vascular endothelial growth factor regulates protein kinase CbetaII (PKCbeta) promoter function in chronic lymphocytic leukaemia cells, stimulating PKCbeta gene transcription via increased association of SP1 and decreased association of STAT3. PMID: 28233872
- Our study suggests that VEGF kinetics is a prognostic factor for locally advanced esophageal squamous cell carcinoma patients receiving curative concurrent chemoradiotherapy. For these patients, lower post-treatment VEGF levels and decreasing levels of VEGF during CCRT are significantly associated with better clinical outcomes. PMID: 30126380
- These results suggest that DMBT can inhibit CNV by down-regulation of VEGF in retina through Akt/NF-kappaB/HIF-1alpha and ERK/Nrf2/HO-1/HIF-1alpha pathway. DMBT might be a promising lead molecule for anti-CNV and serve as a therapeutic agent to inhibit CNV. PMID: 29446046
- the expression of MMIF, HIF-1alpha, and VEGF in the serum and endometrial tissues may be used to assess the stage of endometriosis and the severity of dysmenorrhea. PMID: 30074218
- H3K27me3 and VEGF expression are both significantly associated with overall survival of synovial sarcoma, and H3K27me3 is a significant independent prognostic indicator in patients with synovial sarcoma PMID: 29803658
- Study showed evidence that the VEGF rs699947 polymorphism was obviously associated with an increased risk of bladder cancer and renal cell carcinoma, particularly in Asian population, while no significant association was observed in overall urologic neoplasms. [review] PMID: 30195633
- Low VEGFA expression is associated with Breast Cancer. PMID: 28744693
- these findings indicated that miR655 may inhibit epithelial ovarian cancer (EOC)cell proliferation and invasion by repressing VEGF. Thus, the miR655/VEGF pathway could serve as a novel therapeutic target for patients with EOC. PMID: 29845206
- The VEGF protein expression in gastric cancer tissues is positively correlated with TNM staging and lymph node metastasis in patients. The preoperative prediction results of MRI are well consistent with postoperative pathological results, and MRI features are correlated with lymph node metastasis in patients, which has an important guiding significance for the diagnosis and treatment of gastric cancer. PMID: 30010108
- ADM was an upstream molecule of HIF-1alpha/VEGF and it promoted angiogenesis through upregulating HIF-1alpha/VEGF in epithelial ovarian cancer. PMID: 28091613
- The expression of VEGF was negatively correlated with miR1. PMID: 29845255
- EDF1 is required for VEGF-induced activation of the transcriptional activity of PPARgamma in HUVEC cells. PMID: 29933613
- Studied vascular endothelial growth factor A (VEGFA) gene +936T/C single nucleotide polymorphism; found it has no significant correlation with biliary atresia in the Southern Chinese Han population. PMID: 29251369
- miR125 targeted and inhibited the expression of VEGF through target sites located in the 3' untranslated region of VEGF mRNA. PMID: 29693153
- higher levels of IL-6 and VEGF-A were significantly associated with shorter progression free survival in epithelial ovarian cancer PMID: 29572186
- results suggest that PEDF act as a multipotent factor in the skin and the imbalance of PEDF and VEGF may be responsible for the transformation from normal skin to psoriasis. PMID: 29579411
- RTPCR analysis revealed that the expression levels of COX2 and VEGF were downregulated following morusin treatment... morusin significantly inhibited the proliferation of the lung cancer cell line A549, and may have affected the invasion and migration of the cells by downregulating the expression of tumor angiogenesisrelated genes. PMID: 29749480
- These results suggest that VM formation is increased by EBVLMP1 via VEGF/VEGFR1 signaling and provide additional information to clarify the role of EBVLMP1 in nasopharyngeal carcinoma (NPC)pathophysiology PMID: 29749553
- Data suggest that expression of mRNA for ghrelin and VEGFA are up-regulated in endometrium of women with recurrent miscarriage; thus, ghrelin and VEGFA may play roles in pathogenesis of recurrent miscarriage. These case-control studies were conducted with endometrial tissue obtained during secretory phase of menstrual cycle. (VEGFA = vascular endothelial growth factor A) PMID: 29221937
- AEG-1 was found to be significantly associated with hypoxia in ovarian cancer by regulating the HIF-1alpha/NF-kappaB/VEGF pathway. PMID: 29770329
顯示更多
收起更多
-
相關(guān)疾病:Microvascular complications of diabetes 1 (MVCD1)
-
亞細(xì)胞定位:Secreted. Note=VEGF121 is acidic and freely secreted. VEGF165 is more basic, has heparin-binding properties and, although a significant proportion remains cell-associated, most is freely secreted. VEGF189 is very basic, it is cell-associated after secretion and is bound avidly by heparin and the extracellular matrix, although it may be released as a soluble form by heparin, heparinase or plasmin.
-
蛋白家族:PDGF/VEGF growth factor family
-
組織特異性:Isoform VEGF189, isoform VEGF165 and isoform VEGF121 are widely expressed. Isoform VEGF206 and isoform VEGF145 are not widely expressed. A higher level expression seen in pituitary tumors as compared to the pituitary gland.
-
數(shù)據(jù)庫(kù)鏈接:
Most popular with customers
-
YWHAB Recombinant Monoclonal Antibody
Applications: ELISA, WB, IHC, IF, FC
Species Reactivity: Human, Mouse, Rat
-
Phospho-YAP1 (S127) Recombinant Monoclonal Antibody
Applications: ELISA, WB, IHC
Species Reactivity: Human
-
-
-
-
-
-